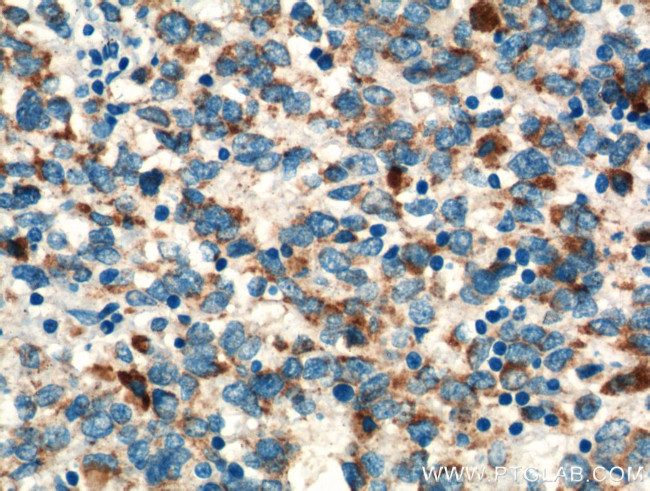
TNF beta Antibody in Immunohistochemistry (Paraffin) (IHC (P))

Search
Proteintech
TNF beta Polyclonal Antibody
{{$productOrderCtrl.translations['antibody.pdp.commerceCard.promotion.promotions']}}
{{$productOrderCtrl.translations['antibody.pdp.commerceCard.promotion.viewpromo']}}
{{$productOrderCtrl.translations['antibody.pdp.commerceCard.promotion.promocode']}}: {{promo.promoCode}} {{promo.promoTitle}} {{promo.promoDescription}}. {{$productOrderCtrl.translations['antibody.pdp.commerceCard.promotion.learnmore']}}
产品信息
13111-1-AP
种属反应
宿主/亚型
分类
类型
抗原
偶联物
形式
浓度
规格
纯化类型
保存液
内含物
保存条件
运输条件
产品详细信息
Immunogen sequence: LPGVGLTPS AAQTARQHPK MHLAHSTLKP AAHLIGDPSK QNSLLWRANT DRAFLQDGFS LSNNSLLVPT SGIYFVYSQV VFSGKAYSPK ATSSPLYLAH EVQLFSSQYP FHVPLLSSQK MVYPGLQEPW LHSMYHGAAF QLTQGDQLST HTDGIPHLVL SPSTVFFGAF AL (35-205 aa encoded by BC034729)
靶标信息
TNF beta, a member of the tumor necrosis factor family, is a cytokine produced by lymphocytes. The protein is highly inducible, secreted, and forms heterotrimers with lymphotoxin-beta which anchor lymphotoxin-alpha to the cell surface. This protein also mediates a large variety of inflammatory, immunostimulatory, and antiviral responses, is involved in the formation of secondary lymphoid organs during development and plays a role in apoptosis. Genetic variations in this gene are associated with susceptibility to leprosy type 4 and psoriatic arthritis.
仅用于科研。不用于诊断过程。未经明确授权不得转售。
生物信息学
蛋白别名: DAMA-25N12.13; hypothetical protein; lymphotoxin alpha isoform b; hypothetical protein; lymphotoxin alpha isoform c; hypothetical protein; lymphotoxin alpha isoform d; hypothetical protein; lymphotoxin alpha isoform e; hypothetical protein; lymphotoxin alpha isoform f; hypothetical protein; lymphotoxin alpha isoform g; LT-alpha; LTA; Lymphotoxin-alpha; TNF b; TNF beta; TNF superfamily, member 1; TNF β; TNF-beta; TNFbeta; TNFβ; tumor necrosis factor beta; tumor necrosis factor ligand 1E; Tumor necrosis factor ligand superfamily member 1; unnamed protein product
基因别名: LT; LTA; TNFB; TNFSF1; TNLG1E
UniProt ID: (Human) P01374
Entrez Gene ID: (Human) 4049